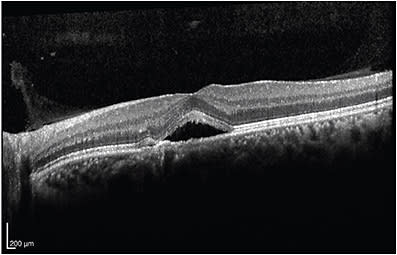
FIGURE 1
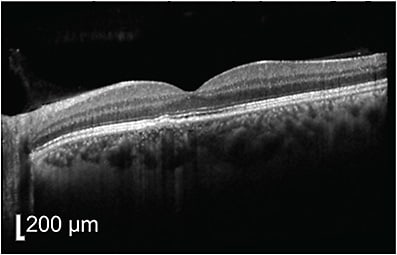
FIGURE 2
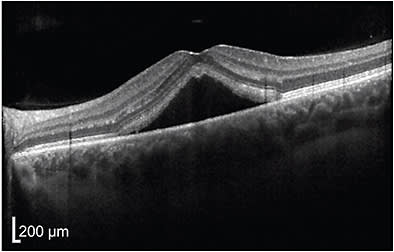
FIGURE 3
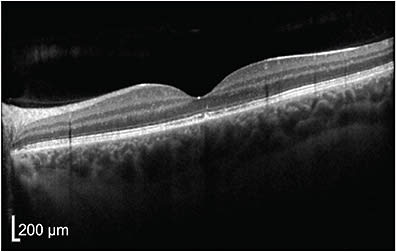
FIGURE 4
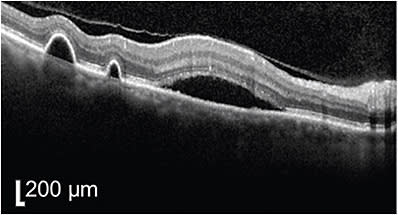
FIGURE 5
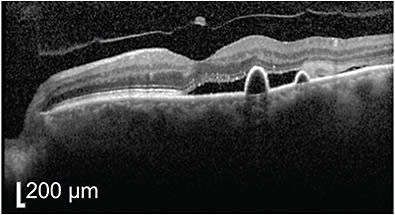
FIGURE 6
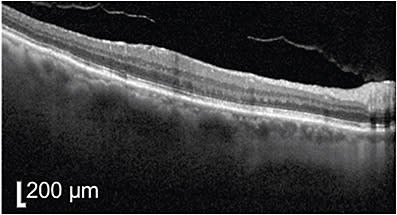
FIGURE 7
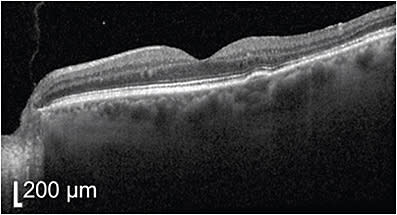
FIGURE 8

With the advent of anti-VEGF treatments for wet age-related macular degeneration (AMD), photodynamic therapy (PDT) with verteporfin (Visudyne; Bausch Health), which had only been introduced and FDA approved 4 years earlier, had been relegated to the second or third line of treatment. With the introduction of even newer drugs, PDT fell further in the esteem of retinal specialists around the world. In 2003, Yanuzzi et al. performed a pilot study using PDT to treat central serous retinopathy (CSR), which showed a statistically significant improvement in vision and fluid in 20 eyes.1 A subsequent meta-analysis of 787 eyes in 2014 showed promise for PDT in CSR.2 So why aren’t we using PDT for CSR more often?
WHY PDT?
Verteporfin, when activated by the 689 nm wavelength light of the PDT device, produces free radicals, which damage the cell membranes comprising the endothelial walls of blood vessels. Typically, verteporfin is “sticky” to bare vessels without an intact endothelium, hence the utility in diseases of neovascularization, such as wet AMD. But in CSR, where the endothelium is damaged and thinned, PDT can be helpful to seal otherwise leaky normal vessels.
Most of us who have graduated fellowship in the anti-VEGF era likely had little to no experience with PDT. Not only do most facilities lack a functioning PDT laser, but the institutional knowledge in most practices continues to fade. Without training in administering the treatment, PDT can seem like a large task for new practices to incorporate into their practice. Adding to that, the lack of a commercially available new PDT laser in the United States makes the hurdle to add PDT to the armamentarium even higher. Used PDT lasers are generally available through resale markets.
The off-label usage of PDT in CSR may lead to some difficulty with insurances as well. In addition, risks of PDT when performed at full fluence in the original wet AMD studies led to acute vision loss, albeit with long-term stability, with some patients developing disciform scars and choroidal infarction.
WHY CSR?
CSR’s classic natural history is that of a self-limited disease, with most patients (90%) resolving within 3 months. However, the typical treatment of stress reduction can be difficult to achieve with some patients, and prolonged fluid accumulation for months on end may lead to photoreceptor loss and permanent vision changes. Color vision disruption as well as persistent metamorphopsia may continue despite a complete anatomical resolution.
Various methods of treatment have been attempted in CSR, including: stress reduction, yoga, and meditation, as well as oral mineralocorticoids, such as spironolactone and eplenerone. Unfortunately, none of these treatments have been shown to be particularly efficacious, especially in the subgroup of patients whose fluid persist beyond 3 months.3
ADMINISTRATION
In CSR, fluorescein angiogram (FA) can be helpful in identifying the causative vessels involved in the leakage. Chronic cases, however, occasionally lose the classic smokestack leakage typically seen in CSR. I often forgo FA entirely and plan treatment solely on OCT imaging. Typically, I plan treatment around the entire area of fluid on OCT as opposed to only the causative vessel. I do this mainly to catch minor areas of leakage beyond those seen on FA. I measure the size of the lesion and add 1000 µm to the total to encompass the whole lesion with ample error to account for imperfect aiming and some patient-induced movement and saccades during the procedure. While I ask for height and weight in determining verteporfin dose, it is mainly to avoid underdosing. In patients with normal height and weight, I typically dose the entire 7 mL reconstituted volume. After dilution to 30 mL with 5% dextrose in water, I infuse the verteporfin over approximately 10 minutes, leaving 5 minutes to place an Area Centralis lens and aim the spot guide over the lesion. I apply 300 mW/cm2, with 25 J/cm2 power density of 689 nm light over 83 seconds. I explain to patients the expectation that there may be some greying of color vision over the course of the next 3 months, but this will grad-ually resolve. I follow up with them 6 weeks after the initial treatment.
CASE 1
A 47-year-old male physician presented initially with a 2-week history of metamorphopsia in the left eye. After 6 months of observation, which did show some initial improvement in central subfield thickness and volume, the improvement stalled despite stress reduction and a 1-month trial of eplenerone. At month 6, progressive retinal pigment epithelium (RPE) atrophy was noted (Figure 1), and the decision was made to undergo half fluence photodynamic therapy with verteporfin. An area of 2800 µm was treated (total area of RPE changes) with 15 mg of verteporfin.
The 6-week check up following PDT showed complete resolution of subretinal fluid, but persistent RPE clumping or plaques subfoveally (Figure 2). Vision remained 20/20 throughout the observation period as well as status post PDT, and the patient reported complete resolution of metamorphopsia.
CASE 2
A 32-year-old male psychologist presented with several days of dark spots and distorted vision in the left eye. He had prior history of severe stress from continuing to see patients during the COVID-19 pandemic, as well as psoriasis. He denied topical or oral steroid use. His vision was 20/20 at presentation.
Despite explaining that most patients resolve on their own within 90 days, the patient insisted on immediate PDT treatment. The patient was educated on the natural history and agreed to wait a month prior to considering additional treatment.
At 1 month, sub-photoreceptor excrescences began to appear (Figure 3), which is, in my experience, a poor prognostic factor for visual outcomes following resolution. The vision had decreased slightly to 20/25, and the patient was notably anxious about the worsening vision and fluid. PDT was performed to an area of 1700 µm with 15 mg of verteporfin. At 6-week follow-up, the patient described complete resolution of his metamorphopsia left eye but his vision remained at 20/25. Drusenoid changes persisted subfoveally (Figure 4).

CASE 3
A 72-year-old man presented to his ophthalmologist with a 1-month history of blurred vision and was referred for macular edema. Upon examination, his vision was 20/60 OD and 20/30 OS. He had multiple pigment epithelial detachments in both eyes, with subretinal fluid in a central serous retinopathy pattern in the right eye (Figures 5-8). Observation was decided upon, despite the possibility that this may represent wet AMD, but complete resolution of subretinal fluid was noted by 1 month.

He returned 6 months later—after having had cataract extraction in both eyes—complaining about the return of metamorphopsia and blurry vision (both eyes). His vision was 20/40 in both eyes at this visit. FA was obtained and showed multiple spots of leakage and large domes of subretinal fluid in both eyes. It was thought that the use of topical steroids preoperatively for the cataract extraction contributed to this flare.
PDT was performed in the right eye and then the left eye on separate visits. Given the wide area of fluid and multiple leakages, a spot size of 4600 µm was performed in both eyes with 15 mg of verteporfin. Complete resolution of subretinal fluid was noted at week 6, and resolution of the PED in both eyes within 7 months. His vision improved to 20/30 right eye and 20/25 left eye. NRP
REFERENCES
- Yannuzzi LA, Slakter JS, Gross NE, et al. Indocyanine green angiography-guided photodynamic therapy for treatment of chronic central serous chorioretinopathy: A pilot study. Retina. 2003;23(3):288-298.
- Erikitola OC, Crosby-Nwaobi R, Lotery AJ, Sivaprasad S. Photodynamic therapy for central serous chorioretinopathy. Eye. 2014;28(8):944-957.
- Lotery A, Sivaprasad S, O’Connell A, et al.; VICI trial investigators. Eplerenone for chronic central serous chorioretinopathy in patients with active, previously untreated disease for more than 4 months (VICI): a randomised, double-blind, placebo-controlled trial. Lancet. 2020;395(10220):294-303.








